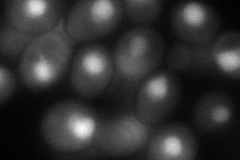

View description
Major of three pyruvate decarboxylase isozymes, key enzyme in alcoholic fermentation, decarboxylates pyruvate to acetaldehyde; subject to glucose-, ethanol-, and autoregulation; involved in amino acid catabolism
Localization:
Intensity:
Fold change:
Significance:
-
C’ GFP library in SD

cytosol2113.27 -
N' NOP1pr-GFP in SD

nucleus648.851 -
N' TEF2pr-mCherry in SD

nucleus0 -
N' NATIVEpr-GFP in SD

missing0 -
N' TEF2pr-VC and Cyto-VN in SD
nucleus89.9154 -
C’ GFP library in SD+DTT

cytosol1579.70.74No -
C’ GFP library in SD+H2O2

nucleusN/AN/AYes -
C’ GFP library in Starvation Media

cytosol3267.781.54Yes -
C’ GFP library on the background of Pup2-DaMP

N/A -
C’ GFP library on the background of CCT mutant

N/A0N/AYes
